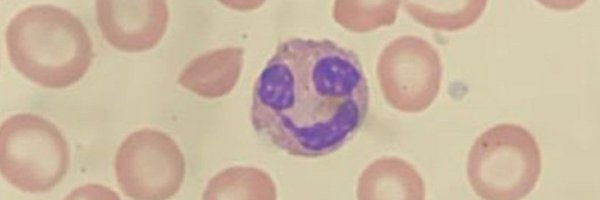

Tarsheen Sethi, MD, MSCI
@tarsheen2
Followers
1K
Following
7K
Media
92
Statuses
4K
Asst Prof @YaleCancer | @womeninlymphoma | T-cell lymphoma #lymsm Investigator | Mom | Poet | Dog-lover || Here for the Science,Trainees and Patients| 🇮🇳🇺🇸
New Haven, CT
Joined March 2014
Excited to have our study combining Mogamulizumab and EPOCH for frontline treatment of aggressive T cell lymphomas including ATLL and transformed CTCL now open at @SmilowCancer @YaleCancer @YaleHematology #tcelllymphoma #lymsm #rarecancers
0
3
10
Novel chemotherapy-free combinations further amplify glofitamab activity and present promising tailored alternatives to SOC treatments. Read the full article in Blood: https://t.co/uqraAcAxdN
0
8
34
Low-dose Nivolumab and Lenalidomide in Relapsed/Refractory Hodgkin Lym... https://t.co/RJTdusAy3Z.
@MathewsVikram @udaypkulkarni @drdatari
2
26
107
Germline CHEK2 variants are identified in 2.2% of cases with early-onset and familial myeloproliferative neoplasms #MPN
https://t.co/4NrsCs9MUe
1
4
29
Polatuzumab vedotin in CNS lymphoma: proof-of-concept study for BBB penetration Pola exhibits sign pre-clinical activity V’s PCNSL & SCNSL xenografts & partially penetrates BBB in CNS lymphoma patients w CSF drug conc reaching 0.56% - 1.31% plasma levels
ashpublications.org
Key Points. Polatuzumab vedotin exhibits significant pre-clinical activity against primary and secondary CNS lymphoma xenografts.Polatuzumab vedotin partia
0
10
39
Best #Heme team ever. What a wonderful celebration of our hematology teams in our annual heme team appreciation day. @YaleCancer @Yale @YaleMed @YaleHematology
1
3
31
Outcome of pts w Mantle Cell Lymphoma after Failure of Anti-CD19 CAR-T Cell Therapy is partic poor: Descar-T Study @LysaLymphoma Bispec Abs appear promising offering durable responses c.f to chemotherapy & targeted therapy @BloodAdvances
ashpublications.org
Key Points. Outcomes of patients with RR mantle cell lymphoma failing CAR-T cell therapy is particularly poor, without standardized salvage option.Bispecif
0
6
16
Patient-reported outcomes in patients with hematologic malignancies treated with CAR T-cell therapy in Europe @BloodAdvances @Kersten_MJ
ashpublications.org
Key Points. Patients treated with CAR T-cell therapy in Europe can achieve a quality of life comparable to that of the European general population.A notabl
0
4
28
New online! Optimizing CAR T cell therapy for solid tumours: a clinical perspective
nature.com
Nature Reviews Clinical Oncology - Chimeric antigen receptor (CAR) T cell therapy is revolutionizing the treatment of haematological malignancies, but expanding applicability to solid tumours...
0
5
6
The Biology of MZL subtypes: Challenge and Relevance of Classification
ashpublications.org
Marginal zone lymphomas (MZLs) are a heterogeneous group of low-grade B-cell neoplasms classified into different entities by the current lymphoma classific
0
6
33
Can’t believe our amazing oncology nurse practitioner Erin Medoff is retiring! She has saved so many lives over the decades & taught me and countless others thru her wisdom and intuitive care for our cancer patients @Dr_AmerZeidan @YaleCancer
0
3
28
Around 20% of patients with DLBCL received 2L treatment, with a 5-year OS of 26%, influenced by age, relapse timing, and treatment intent. https://t.co/f5rKlQSWPS
#lymphoidneoplasia
0
9
30
Chronic lymphocytic leukemia (CLL) cells reprogram their tumor microenvironment (TME) to promote drug resistance and tumor progression. Authors 3D approach reveals that CLL B cells upregulate the AP-1 transcription factor, conferring protection against therapy-induced cell death.
0
2
16
Tonight at 7:30pm, Dr. Nikolai Podoltsev @YaleHematology joins #YaleCancerAnswers for a conversation on #leukemia, including AML, ALL, and chronic myeloid leukemia. 🎧Listen live @wnpr 🔁Download @ApplePodcasts 💻Watch @YouTube
@SmilowCancer #leukemiaandlymphomaawarenessmonth
0
1
10
Rituximab, bendamustine, and cytarabine followed by venetoclax in olde...
1
7
24
Our annual Review of Advances in Oncology: Highlights from the @ASCO Annual Meeting #ASCO25 begins! We’re looking forward to a full day of updates and connections. @DrRoyHerbstYale @SmilowCancer @YaleMed @YNHH
1
4
15
These are fantastic. Lovely graphics too. I’d only add that Hans IHC, while admittedly imperfect, is a very reasonable surrogate for the increased activity of polatuzumab in ABC LBCL, thus pola-R-CHP is not just one but THE standard of care for patients with non-GCB disease.
The 2025 LBCL Guidelines are out ! Fantastic work made by the @EHA_Hematology Cc @c_thieblemont
https://t.co/OR8RZ95Wt3
0
4
10
How I manage patients with unexplained cytopenia [Apr 10, 2025] Malcovati & Cazzola @BloodPortfolio
https://t.co/bfCmp1AJ4R
#camoldx #PrecisionMedicine
0
35
182
A study led by @Terri_ParkerMD finds Isatuximab demonstrated substantial efficacy in previously treated patients with #ALamyloidosis and was associated with a good safety profile. https://t.co/WQqUg0c61T
@SmilowCancer @BloodPortfolio @YaleHematology
ashpublications.org
Key Points. Isatuximab in relapsed and/or refractory AL amyloidosis resulted in an overall hematologic response rate of 77%.The high rates of hematologic r
0
5
9
Drug development in MZL: caring for the forgotten child @BloodPortfolio @c_thieblemont #Sylvain Carras @ComeBommier
ashpublications.org
Marginal zone lymphoma (MZL) encompasses biologically heterogenous group of indolent B-cell lymphomas that remains substantially underrepresented in clinic
0
6
11